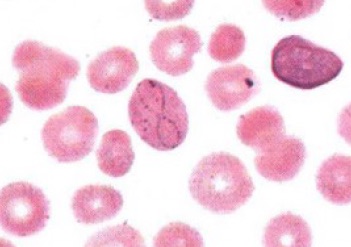
13.jpg

benshenmed(官方) 2020年08月20日
形态学 152
红细胞内结构:卡波环(Cabot ring):RBC胞质中紫红色细线圈状结构,呈环形或8字形
临床意义:恶性贫血、溶血性贫血、铅中毒、白血病、巨幼细胞性贫血、增生性贫血和脾切除后

全屏 最小
benshenmed(官方) 2020年08月20日
形态学 152
红细胞内结构:卡波环(Cabot ring):RBC胞质中紫红色细线圈状结构,呈环形或8字形
临床意义:恶性贫血、溶血性贫血、铅中毒、白血病、巨幼细胞性贫血、增生性贫血和脾切除后
全屏 最小
检验速记关闭
APP下载